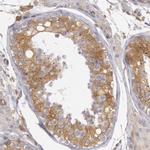
IKK beta Antibody in Immunohistochemistry (Paraffin) (IHC (P))

Search
Invitrogen
IKK beta Polyclonal Antibody
{{$productOrderCtrl.translations['antibody.pdp.commerceCard.promotion.promotions']}}
{{$productOrderCtrl.translations['antibody.pdp.commerceCard.promotion.viewpromo']}}
{{$productOrderCtrl.translations['antibody.pdp.commerceCard.promotion.promocode']}}: {{promo.promoCode}} {{promo.promoTitle}} {{promo.promoDescription}}. {{$productOrderCtrl.translations['antibody.pdp.commerceCard.promotion.learnmore']}}

Please note: We are reviewing Western blot images included in the antibody testing data in our catalog, including those provided by third parties. Unless expressly labeled or annotated as “raw-unedited”, Western blot images included in the antibody testing data in our catalog may have been edited, optimized or otherwise adjusted for presentation.
产品信息
PA5-81927
种属反应
宿主/亚型
分类
类型
抗原
偶联物
形式
浓度
规格
纯化类型
保存液
内含物
保存条件
运输条件
RRID
产品详细信息
Immunogen sequence: PNGCFKALDD ILNLKLVHIL NMVTGTIHTY PVTEDESLQS LKARIQQDTG IPEEDQELLQ EAGLALIPDK PATQCISDGK LNEGHTLDMD LVFLFDNSKI TYETQISPRP QPESVSCILQ EPKRNLAFFQ LRKVWGQVWH
Highest antigen sequence indentity to the following orthologs: Mouse - 89%, Rat - 87%.
靶标信息
Phosphorylation of serine residues on the I-kappa-B proteins by IKK kinases, including IKBKB, marks them for destruction via the ubiquitination pathway, allowing activation of the NF-kappa-B complex. Inhibitor of nuclear factor kappa-B kinase subunit beta (IKK beta) is a serine kinase that plays an essential role in the NF-kaapa-B signaling pathway which is activated by mulitple stimuli such as inflammatory cytokines, bacterial, or viral products, DNA damages, or other cellular stresses. IKK beta acts as part of the canonical IKK complex in the conventional pathway of NF-kappa-B activation and phosphorylates inhibitors of NF-kappa-B on 2 critical serine residues. These modifications allow polyubiquitination of the inhibitors and subsequent degradation by the proteasome. In turn, free NF-kappa-B is translocated into the nucleus and activates the transcription of hundreds of genes involved in immune response, growth control, or protection against apoptosis. Mutations affecting the IKK beta gene can result in Immunodeficiency 15 (IMD15).
仅用于科研。不用于诊断过程。未经明确授权不得转售。
篇参考文献 (0)
生物信息学
蛋白别名: FLJ40509; I-kappa-B kinase 2; I-kappa-B-kinase beta; IKK-2; Inhibitor of nuclear factor kappa-B kinase subunit beta; MGC131801; NFKBIKB; Nuclear factor NF-kappa-B inhibitor kinase beta; Serine/threonine protein kinase IKBKB
基因别名: IKBKB; IKKB
Entrez Gene ID: (Human) 3551




